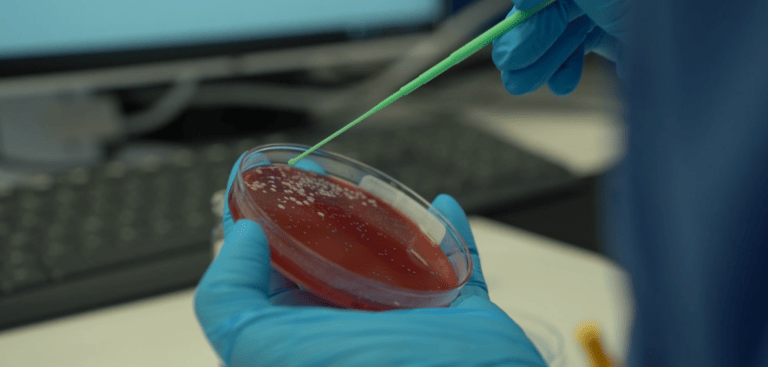

Centottantamila campioni biologici l’anno, cinquecento ogni giorno, esaminati da una catena di analisi automatica. In pochi minuti, può individuare la presenza o meno di un batterio e fornisce, in tempi brevi, la risposta terapeutica personalizzata per il paziente.
È la tecnologia più sofisticata a disposizione del nuovo laboratorio di Microbiologia provinciale della ASL. Unico al Sud Italia, tra i pochi esempi in Italia. Azzerati i tempi di analisi e diagnosi, migliore qualità e maggiore sicurezza per gli operatori, a costi ridotti rispetto al passato.
L’Ospedale Di Venere, è stato visitato oggi dal presidente della Regione Michele Emiliano, accompagnato dal direttore generale della ASL, Antonio Sanguedolce e dal direttore del Dipartimento di Medicina di Laboratorio e Trasfusionale, Edmondo Adorisio.
Il laboratorio è dotato di una innovativa isola di Batteriologia completamente automatizzata capace di processare ogni anno 180mila campioni per l’intero territorio provinciale, oltre che di attrezzature ultra moderne, di alta specializzazione, che hanno rivoluzionato le analisi di laboratorio, soprattutto nella riduzione dei tempi, assicurando la qualità delle indagini, la massima sicurezza per gli operatori e una migliore economia di scala, per la ottimizzazione delle risorse. Le tecnologie presenti e le procedure standardizzate messe a punto dai medici della ASL rendono il laboratorio di Microbiologia del Di Venere un unicum nel sud Italia e tra i pochi presenti sul territorio nazionale.
«Questo centro è il primo esempio concreto – dichiara il presidente della Regione, Michele Emiliano – del modello organizzativo innovativo per la Patologia clinica che la Regione ha avviato nel 2017 con un atto deliberativo finalizzato alla revisione della rete pubblica, organizzata in laboratori Hub, e in aggregazioni formate da laboratori spoke di base, spoke d’urgenza e centri prelievi territoriali. L’Ospedale Di Venere è oggi hub per tutte le analisi della provincia, è dotato di macchinari unici in Italia e rari in Europa, che riducono i rischi per gli operatori, compresi i rischi derivanti dagli errori manuali e riescono a selezionare virus e batteri, identificando con precisione i farmaci che servono a contrastarli. Si riducono i tempi di degenza e si abbattono i costi degli antibiotici. In passato questo laboratorio riusciva a gestire 50 campioni al giorno, oggi 500».
La struttura – ampia 1000 metri quadrati – ospita tutta la Microbiologia provinciale insieme ad altri settori di alta specializzazione: virologia, allergologia, biologia molecolare, preanalitica, autoimmunità, tossicologia, area urine. Le indagini microbiologiche quotidiane sono prevalentemente dedicate a: urinocolture, tamponi faringei, tamponi vaginali, indagini su cateteri chirurgici e non, tutte analisi che fino a poco tempo fa erano manuali.
Anche l’esame delle urine è totalmente automatizzato, con una capacità di esecuzione di 1100 campioni in un’ora dove l’operatore non mette mano, carica i campioni, che vengono lavorati sia con metodica citofluorimetrica che con metodica microscopica.
«Abbiamo importato nella Medicina di laboratorio – dichiara il dg della ASL, Antonio Sanguedolce – modelli industriali internazionali che oggi rendono questo laboratorio un centro dalle elevatissime capacità organizzative e gestionali. Qui è in funzione – continua – una catena di analisi efficientissima che raccoglie tutti i campioni biologici provenienti dalla ASL, da nord a sud. L’intervento di riordino della Medicina di Laboratorio – continua – ha consentito di razionalizzare l’operatività del personale addetto e ottimizzare le procedure analitiche, garantendo la sicurezza degli operatori sanitari dai rischi biologici, la qualità degli esami e il contenimento dei costi di esercizio dei sistemi diagnostici».
Le apparecchiature più innovative si trovano nell’area di batteriologia, completamente robotizzata, dove è stato creato un back up strumentale, per cui si può essere operativi h24 e, in caso di guasto di una macchina, ne subentra una seconda grazie al disaster recovery, un sistema che va a ripristinare la funzionalità dell’apparecchiatura.
«Quello che fino a poco tempo fa gli operatori del Laboratorio facevano a mano – spiega il dottor Edmondo Adorisio, direttore del Dipartimento di Medicina di Laboratorio e Trasfusionale – oggi è tutto robotizzato: il prelievo del campione dalla provetta, la scelta delle piastre di coltura, la semina e l’incubazione, durante la quale viene scattata un’immagine in digitale per la lettura da parte del microbiologo per scoprire eventuali patogeni, vengono effettuati in piena sicurezza per gli operatori. La tecnologia – aggiunge – ha azzerato i tempi di attesa, e con i vantaggi della automazione, ci possiamo permettere di concentrare in un solo posto tutti gli esami, con un solo operatore in cabina di validazione digitale e un tecnico che carica i campioni. Questo non significa che è in atto una riduzione del personale – conclude – anzi è stato potenziato con nuove assunzioni, ma vengono ridotte le attività a basso valore aggiunto, e ottimizzate le risorse, usando il personale per l’alta specializzazione e per esami di secondo livello».
Un’isola microbiologia unica in Puglia e nel sud Italia
A spiegare come funziona il sistema innovativo, è il dottor Giuseppe Gagliardi, responsabile della UOSVD di Microbiologia. «L’isola batteriologica – argomenta – è composta da una struttura suddivisa in vari moduli. Il primo modulo è composto da piastre di vetro con terreni di coltura dove vengono posizionati i campioni, a loro volta seminati in automatico attraverso biglie magnetiche che richiamano protocolli standardizzati che hanno definito i medici del laboratorio. Il secondo modulo – aggiunge Gagliardi – è costituito dagli incubatori – sono tre, due ad ossigeno e uno a Co2 – dove le piastre vengono incubate e monitorizzate continuamente attraverso letture a distanza in camere digitali che catturano le immagini. Le immagini vengono poi visionate dai dirigenti medici che individuano la presenza o meno di colonie batteriche».
Gli step successivi sono l’identificazione del batterio e l’antibiogramma batterico, che avvengono in appena 5 minuti. Grazie alla rapida identificazione, il personale di laboratorio può comunicare direttamente al reparto l’esito e orientare il prima possibile la terapia antibiotica a cui sottoporre il paziente.
Area per testare la tubercolosi e la biologia molecolare
Il centro è dotato di un’area a pressione negativa dedicata alla diagnosi della tubercolosi, con personale altamente qualificato. Si eseguono test e colture, ma anche indagini simultanee di biologia molecolare con un elevato livello qualitativo del personale, che viene dedicato a tecnologie ad alta automazione che danno risultati precisi ed efficienti.
Emocolture
All’interno del laboratorio di microbiologia è operativo uno strumento per le emocolture che ha sei apparecchiature “gemelle” nei laboratori spoke della ASL. Lo strumento serve per la valutazione delle emocolture nei laboratori satelliti: dal momento in cui vengono inserite le boccette, il sistema centralizzato le controlla e le valida. I test con esito positivo vengono inviati al Di Venere, analizzati e gestiti a livello della catena microbiologica. Il vantaggio di questo sistema è la standardizzazione delle operazioni e una migliore capacità analitica senza precedenti.
Opere strutturali
Il progetto di riqualificazione del Laboratorio – redatto dall’ Ingegnere Nicola Pantzartzis con il coordinamento dell’Area tecnica aziendale – è stato finanziato per un importo complessivo di 3 milioni e 530mila euro, provenienti dal “Fondo per lo sviluppo e la coesione 2014-2020”. I lavori hanno interessato un complesso di tre piani, seminterrato, piano rialzato e primo piano, per una superficie totale di circa 2mila metri quadri. Il seminterrato ospita i depositi e le centrali tecnologiche, mentre il piano rialzato che – a breve sarà ufficialmente aperto – è sede dell’Hub di Patologia clinica della ASL.
Il primo piano, che si sviluppa in 1000 metri quadri, ospita l’isola batteriologica automatizzata, oltre a: locali spogliatoio con annessi servizi igienici dedicati, locali medici, sala riunioni e locale relax, servizi igienici per gli operatori e un ulteriore servizio per persone con disabilità.
Ai lavori strutturali si sono affiancati quelli per l’allestimento del laboratorio, costato 665mila euro e interamente finanziato con fondi Fesr 2014-2020.
Qualità dell’ambiente di lavoro e sicurezza degli operatori
Un’altra caratteristica del nuovo laboratorio è la qualità dell’ambiente di lavoro: le strumentazioni e le tecnologie sono state realizzate nel rispetto della qualità dell’ambiente lavorativo, con un notevole abbattimento dell’inquinamento acustico, del calore e del rumore.
Celeste Francavilla, tecnico biomedico di laboratorio, racconta: “Il lavoro nel nuovo laboratorio – spiega l’operatrice – è migliore per diversi motivi, dà risultati certi e sicuri in caso di positività e ha migliorato anche la mia vita lavorativa. Non metto più mani sui materiali, mi sento più sicura, migliora il margine di errore, è una vera e propria rivoluzione, dall’inizio del processo fino alla fine”.